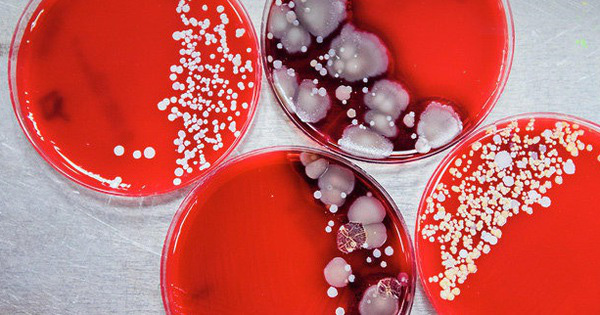

Theo một cuộc khảo sát của hãng kiểm toán Deloitte, người Mỹ kiểm tra điện thoại của họ khoảng 47 lần trong ngày, tạo ra rất nhiều cơ hội để vi sinh vật di chuyển từ ngón tay đến điện thoại. Có một sự thật đáng buồn rằng, chính bàn tay của chúng ta là thủ phạm lớn nhất trong việc khiến điện thoại trở nên mất vệ sinh.

Ảnh: Internet
Emily Martin, một nhà nghiên cứu về dịch tễ học tại Trường Y tế Công cộng thuộc Đại học Michigan (Mỹ) cho biết: "Vì mọi người luôn mang theo điện thoại di động, ngay cả trong những tình huống mà họ thường rửa tay trước khi làm bất cứ điều gì, điện thoại di động có xu hướng trở nên khá mất vệ sinh".
Nghiên cứu trên không chỉ ra trung bình có bao nhiêu vi trùng đang bò trên điện thoại di động, nhưng một nghiên cứu gần đây đã phát hiện có hơn 17.000 loại vi khuẩn trên điện thoại của một học sinh trung học. Các nhà khoa học thuộc Đại học Arizona (Mỹ) đã phát hiện ra rằng điện thoại di động mang nhiều vi khuẩn gấp 10 lần so với hầu hết các bồn cầu trong nhà vệ sinh.

Ảnh: Internet
Susan Whittier, giám đốc khoa vi sinh học lâm sàng tại New York-Presbyterian và Trung tâm Y tế Đại học Columbia cho biết: "Chúng ta không sống trong một môi trường vô trùng, vì vậy nếu bạn chạm vào một bề mặt bất kỳ thì sẽ có thứ gì đó bám theo bạn". Nhiều nghiên cứu đã phát hiện ra các mầm bệnh nguy hiểm trên điện thoại di động, bao gồm Streptococcus, MRSA và thậm chí là E.coli. Mặc dù những vi khuẩn bám trên điện thoại sẽ không tự động làm cho người dùng bị bệnh, chúng có thể đóng vai trò tác nhân gây bệnh.
Ảnh: Internet
Để tránh việc lây lan vi trùng, virus gây bệnh qua điện thoại, cả Martin và Whittier đều cho rằng cần tránh sử dụng thiết bị này trong phòng tắm, nhà vệ sinh. Khi đi vệ sinh, mầm bệnh ở khắp mọi nơi, đó là cách điện thoại tiếp xúc với vi khuẩn như E. coli.
Ngoài ra, người ta cũng nên thường xuyên lau sạch điện thoại</> bằng một miếng vải mềm. Để giúp tẩy trùng tốt hơn, chúng ta nên nhúng miếng vải vào hỗn hợp 60% nước và 40% cồn. Tuy nhiên, việc sử dụng loại cồn đậm đặc cũng dễ ảnh hưởng xấu đến màn hình điện thoại. Các chuyên gia về công nghệ đề xuất sử dụng những loại dung dịch chuyên dụng để tẩy trùng cho điện thoại, không chứa chất Ammonia hay chất cồn gây nguy hại đến điện thoại. Kết hợp với vệ sinh điện thoại, giải pháp đơn giản và hiệu quả hơn để tránh vi khuẩn là cần phải rửa tay vài lần một ngày bằng nước rửa tay.

Việc bạn cần làm bây giờ là đến ngay các của hàng uy tín để tìm mua 1 chai dung dịch vệ sinh chuyên dụng cho điện thoại, lưu ý nên đọc kỹ thành phần trên chai dung dịch trước khi thanh toán. Hoặc bạn có thể làm khảo dung dịch vệ sinh Jcpal bên trên, vì nó đáp ứng đủ tiêu chuẩn vệ sinh cũng như không chứa những thành phần gây hại cho điện thoại cũng như thân thiện với môi trường.